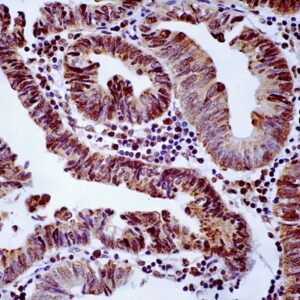
Hsa-miR-221-3p Probe

miRNA Probes
BioGenex has pioneered the development of miRNA research and diagnostics tools with leading-edge products. Currently, we offer over 240 ready-to-use (RTU) Super Sensitive™ Nucleic Acid (SSNA) miRNA ISH probes for accurate and early tumor diagnosis. These probes are sensitive enough to detect low-abundant miRNA(s) that are often required to identify biomarkers. They have a high melting temperature enabling stringent washes to remove non-specific binding. BioGenex miRNA probes are dual-end labeled with an anti-fluorophore to amplify the signal and yield clean and intense staining.